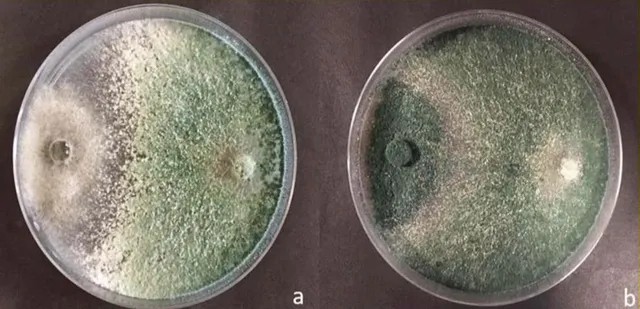
BIOCONTROLADORES

Biotecnología Sustentable para el Agro

El Futuro del Agro es Biointeligente
Somos una empresa que se especializa en ofrecer productos para el agro basados en la sustentabilidad, medio ambiente y tecnología. Acompañamos a los agricultores a impulsar prácticas sustentables en el largo plazo. Estas contribuyen con el cuidado del medio ambiente y la optimización de los recursos de los cuales depende, satisfaciendo las necesidades básicas de alimentos, siendo económicamente viable y mejorando la calidad de vida del productor y la sociedad. En Aguafértil utilizamos las nuevas tecnologías, bio y nanopartículas aplicadas al agro. Nuestra gran paleta de productos se basa en: materia orgánica compostada, biofertilizantes, bioestimulantes foliares, nanopartículas correctoras de suelo, microorganismos benéficos, biocontroladores y todo para el agro.
"Damos vida a tu suelo"
Nuestros Productos y Tecnologías

MATERIA ORGÁNICA COMPOSTADA
Presente en forma líquida y sólida en pelet. Nuestro compost fertiliza, mejora la estructura del suelo y aumenta la retención de agua y nutrientes.

BIOFERTILIZANTES
Abonos y Fertilizantes compuestos con N - P - K y Micronutrientes con incorporación de microorganismos benéficos que mejoran la disponibilidad de nutrientes.

BIOESTIMULANTES FOLIARES
Aminoácidos, Polifenoles y Fosfitos. Potencian el crecimiento y la resistencia al estrés de las plantas.

NANOPARTÍCULAS CORRECTORAS DE SUELOS
Tecnología de vanguardia para maximizar resultados. Optimizan el pH, corrigen suelos salinos sódicos y mejoran la estructura del suelo para su máxima producción.

MICROORGANISMOS BENÉFICOS
Son el motor biológico del suelo. Transforman el alimento para las plantas. Cambian el aspecto físico y químico del suelo. Son esenciales para tu cultivo.
BIOCONTROLADORES
Hongos y bacterias que actúan como insecticidas y fungicidas naturales contra plagas y enfermedades.
¡Juntos hacemos crecer la tierra con innovación!
Descubre todas las marcas que distribuimos y lleva tu campo al siguiente nivel
SOLICITAR CATÁLOGOMarcas que Distribuimos
En San Juan y La Rioja










Trabajamos con productos Orgánicos Certificados con normas para la Unión Europea, EEUU y Japón





Beneficios de Trabajar con Nosotros
Asesoramiento Profesional
Te acompañamos en cada etapa con expertos en nutrición vegetal
Tecnología Avanzada
Bio y nanopartículas de última generación para tu campo
Sustentabilidad
Cuidamos el medio ambiente y optimizamos recursos
Soporte Completo
Préstamo de maquinaria y seguimiento continuo
Productores Asesorados
Años de Experiencia
Tecnologías Disponibles
Conocé los testimonios en nuestras redes sociales
Síguenos en Instagram, YouTube y Spotify
Preguntas Frecuentes
Respondemos tus consultas

Contactanos
Estamos aquí para ayudarte a llevar tu campo al siguiente nivel
Información de Contacto
¿Por qué elegirnos?
- Asesoramiento profesional gratuito
- Tecnologías de última generación
- Préstamo de maquinaria
- Seguimiento continuo
Nuestra Ubicación
Encuéntranos en San Juan, Argentina
Horario
Lunes a Viernes
9:00 - 18:00 hs
Teléfono
+54 (264) 444-7953



